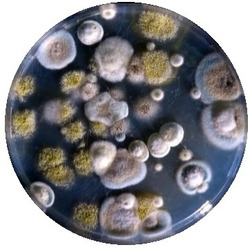
Развивающая игра Царство грибов

Развивающая игра Царство грибов — это учебное оборудование для школ и детских садов. Соответствует ФГОС и Приказу 838 Минпросвещения, поставляется по 44-ФЗ с документами для госзакупки, сертификатами ЕАЭС и гарантией производителя.
Каталог «Учебного стандарта» — 2965 позиций в 40 категориях по ФГОС и Приказу 838 Минпросвещения (перечень средств обучения). Поставка по 44-ФЗ и 223-ФЗ с полным пакетом документов, сертификаты ЕАЭС, гарантия производителя. Доставка по всей России — 3–14 дней со склада в Ангарске.
Развивающая игра Царство грибов — развивающие игры
Развивающая научная игра от «Научных развлечений» для формирования интереса к науке у детей дошкольного и младшего школьного возраста.
Характеристики и комплектация
Назначение С помощью набора “Тайны микробиологии. Царство грибов”* вы узнаете удивительный мир организмов, которые постоянно обитают вокруг нас, но которые мы не замечаем. Вы также сможете поучаствовать в создании этого мира — вырастить красивейшие колонии грибов-микромицетов, узнать как бороться с плесенью и как подчинить ее себе, увидеть микромицеты во всех окружающих нас средах. Нас окружает невидимый мир микроскопических живых существ. Мы их едим, пьем, вдыхаем с каждым вдохом и выдыхаем обратно, они “смотрят” на нас со стен наших квартир, а мы даже не замечаем этого. Работа с набором позволит проникнуть в принципы развития грибов, в тонкости взаимоотношений между грибами, а также грибов и других микроорганизмов. В состав набора входит: чашка Петри (45 шт.), минеральная основа среды Чапека, колба коническая, агар, ложка для дозирования, сухое горючее, парафильм, пинцет и другие материалы и оборудование, необходимые для проведения экспериментов. *Набор не следует использовать людям с аллергическими заболеваниями и ослабленным иммунитетом. Внимание! Набор "Царство грибов" продается исключительно для образовательных организаций и только по предварительному заказу. Опыты: Знакомство с подданными (6 опытов) Поиск новых подданных (9 опытов) Условия роста подданных (4 опыта) Грибы-воины (4 опыта)Применение в образовательном процессе
Оборудование применяется в образовательном процессе для проведения практических занятий, лабораторных работ и демонстрационных экспериментов. Соответствует требованиям ФГОС и Приказа № 838 Минпросвещения от 28.11.2024 к оснащению образовательных учреждений.
Преимущества
- Соответствует ФГОС и Приказу № 838 Минпросвещения
- Приоритет при госзакупках по 44-ФЗ для продукции из реестра Минпромторга (ПП РФ № 719, ПП РФ № 616)
- Сертификат соответствия ЕАЭС
- Полная комплектация с документацией
- Гарантия производителя
- Работаем по 44-ФЗ и 223-ФЗ — полный пакет документов для госзакупок
Купить Развивающая игра Царство грибов в Учебный стандарт
Компания «Учебный стандарт» (ИНН 3801158281) — официальный поставщик образовательного оборудования с 2018 года. Поставляем оборудование, включённое в реестр промышленной продукции Минпромторга (ПП РФ № 719). Предоставляем выписку из реестра, сертификаты ЕАЭС. Предоставляем счета-фактуры, товарные накладные и гарантийные талоны. Работаем по 44-ФЗ и 223-ФЗ. Доставка по всей России от 3 рабочих дней. Для расчёта коммерческого предложения: +7 (904) 115-00-56, fgostorg.ru@yandex.ru.
Произведено компанией «Научные развлечения» (Россия). Бренд «Наураша» — лидер российского рынка цифровых лабораторий для дошкольного и начального образования. Сертифицировано по ФГОС. Входит в перечень Приказа 838 Минпросвещения. Реестр Минпромторга ПП РФ №719.
🤖 Спросить о нас в нейросетях: